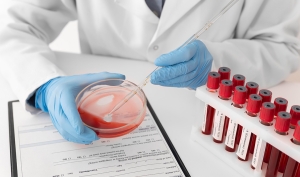
gazi-hastanesi-hematoloji

Hematoloji
Hematoloji bilim dalı, kan ve kemik iliği gibi kanı oluşturan organları ve kanla ilgili rahatsızlıkları ve hastalıkları inceler.
Hemoglobinopatilerde tanı, tedavi ve genetik danışmanlık; lenfoma, lösemiler ve koagülasyon bozukluklarının tanı ve tedavisi gibi geniş çaplı hematoloji hizmetleri vermektedir.